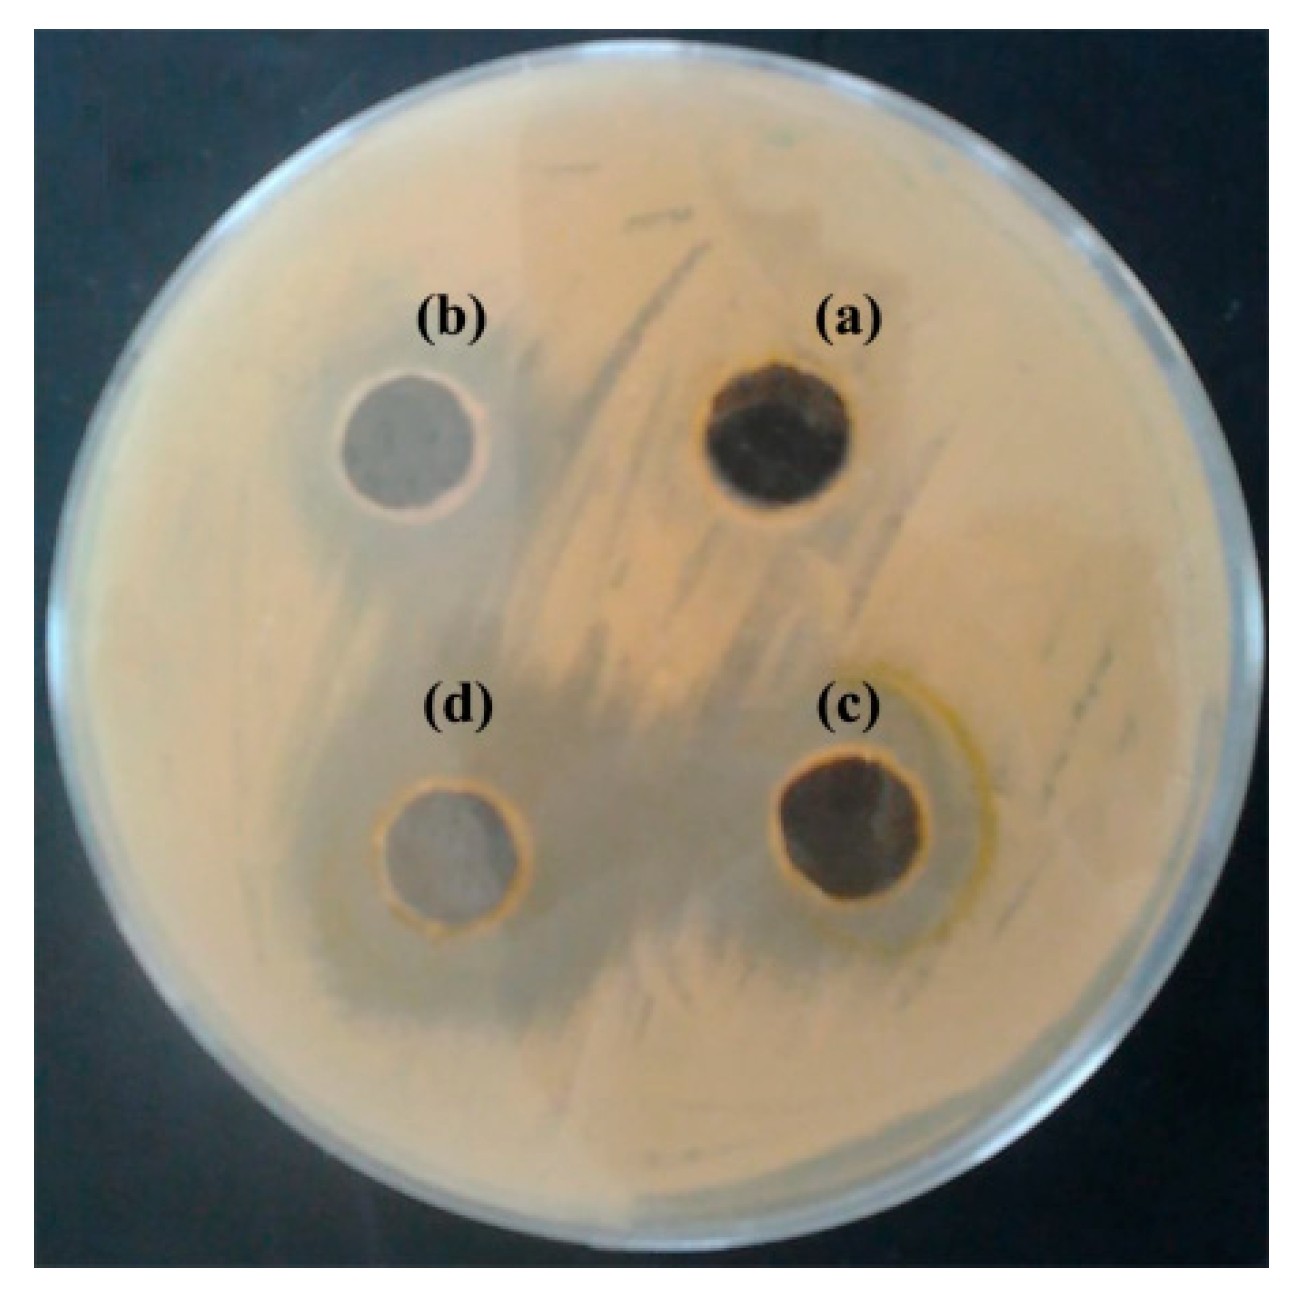
Antibiotics 11 00489 g003

Anti-Salmonella and Antibiofilm Potency of Salvia officinalis L. Essential Oil against Antibiotic-Resistant Salmonella enterica
Abstract
:1. Introduction
2. Materials and Methods
2.1. Chemicals
2.2. Samples Collection and Bacterial Isolation
2.3. Testing for Microorganism Sensitivity
2.4. Collection and Identification of Plants
2.5. Extraction of Salvia Essential Oil (SEO)
2.6. GC and GC-MS Analysis Conditions of EO
2.7. Anti-Salmonella Activity and Minimum Inhibitory Concentration (MIC) Assay
2.8. In Vitro Time-Kill Curve of EO on the Growth of Salmonella
2.9. Antibiofilm Tests
2.10. Statistical Analysis
3. Results
3.1. Drug Resistance of S. enterica Isolates toward Antimicrobial Drugs
3.2. Antibacterial Activity of S. officinalis L. EO on S. enterica Isolates
3.3. Effect of S. officinalis L. EO on Viability of S. enterica
3.4. Effect of S. officinalis L. EO on Biofilm Growth of S. enterica Isolates
3.5. Chemical Characterization of S. officinalis L. EO by GC
4. Discussion
5. Conclusions
Author Contributions
Funding
Data Availability Statement
Acknowledgments
Conflicts of Interest
References
- Dhanashekar, R.; Akkinepalli, S.; Nellutla, A. Milk-Borne Infections. An Analysis of Their Potential Effect on the Milk Industry. Germs 2012, 2, 101–109. [Google Scholar] [CrossRef]
- Oliver, S.P.; Jayarao, B.M.; Almeida, R.A. Foodborne Pathogens in Milk and the Dairy Farm Environment: Food Safety and Public Health Implications. Foodborne Pathog. Dis. 2005, 2, 115–129. [Google Scholar] [CrossRef] [Green Version]
- Todd, E.C.D. Foodborne Disease and Food Control in the Gulf States. Food Control. 2017, 73, 341–366. [Google Scholar] [CrossRef]
- Rotimi, V.O.; Jamal, W.; Pal, T.; Sonnevend, A.; Dimitrov, T.S.; Albert, M.J. Emergence of Multidrug-Resistant Salmonella spp. and Isolates with Reduced Susceptibility to Ciprofloxacin in Kuwait and the United Arab Emirates. Diagn. Microbiol. Infect. Dis. 2008, 60, 71–77. [Google Scholar] [CrossRef]
- World Health Organization. Brucellosis in Humans and Animals; Weltgesundheitsorganisation, FAO, OIE—World Organisation for Animal Health, Eds.; World Health Organization: Geneva, Switzerland, 2006; ISBN 978-92-4-154713-0. [Google Scholar]
- Bin-Jumah, M.; Abdel-Fattah, A.-F.M.; Saied, E.M.; El-Seedi, H.R.; Abdel-Daim, M.M. Acrylamide-Induced Peripheral Neuropathy: Manifestations, Mechanisms, and Potential Treatment Modalities. Environ. Sci Pollut Res. 2021, 28, 13031–13046. [Google Scholar] [CrossRef]
- Ezzati, M.; Lopez, A.D.; Rodgers, A.; Vander Hoorn, S.; Murray, C.J. Selected Major Risk Factors and Global and Regional Burden of Disease. Lancet 2002, 360, 1347–1360. [Google Scholar] [CrossRef]
- Gal-Mor, O.; Boyle, E.C.; Grassl, G.A. Same Species, Different Diseases: How and Why Typhoidal and Non-Typhoidal Salmonella Enterica Serovars Differ. Front. Microbiol. 2014, 5, 391. [Google Scholar] [CrossRef] [Green Version]
- Eng, S.-K.; Pusparajah, P.; Ab Mutalib, N.-S.; Ser, H.-L.; Chan, K.-G.; Lee, L.-H. Salmonella: A Review on Pathogenesis, Epidemiology and Antibiotic Resistance. Front. Life Sci. 2015, 8, 284–293. [Google Scholar] [CrossRef] [Green Version]
- Chen, H.-M.; Wang, Y.; Su, L.-H.; Chiu, C.-H. Nontyphoid Salmonella Infection: Microbiology, Clinical Features, and Antimicrobial Therapy. Pediatr. Neonatol. 2013, 54, 147–152. [Google Scholar] [CrossRef] [Green Version]
- Black, P.H.; Kunz, L.J.; Swartz, M.N. Salmonellosis—A Review of Some Unusual Aspects. N. Engl. J. Med. 1960, 262, 811–817. [Google Scholar] [CrossRef]
- Klein, N.C.; Cunha, B.A. Third-Generation Cephalosporins. Med. Clin. N. Am. 1995, 79, 705–719. [Google Scholar] [CrossRef]
- Ventola, C.L. The Antibiotic Resistance Crisis: Part 1: Causes and Threats. Pharm. Ther. 2015, 40, 277–283. [Google Scholar]
- Founou, L.L.; Founou, R.C.; Essack, S.Y. Antibiotic Resistance in the Food Chain: A Developing Country-Perspective. Front. Microbiol. 2016, 7, 1881. [Google Scholar] [CrossRef] [PubMed]
- Collenburg, L.; Beyersdorf, N.; Wiese, T.; Arenz, C.; Saied, E.M.; Becker-Flegler, K.A.; Schneider-Schaulies, S.; Avota, E. The Activity of the Neutral Sphingomyelinase Is Important in T Cell Recruitment and Directional Migration. Front. Immunol. 2017, 8. [Google Scholar] [CrossRef] [PubMed] [Green Version]
- Marshall, B.M.; Levy, S.B. Food Animals and Antimicrobials: Impacts on Human Health. Clin. Microbiol. Rev. 2011, 24, 718–733. [Google Scholar] [CrossRef] [Green Version]
- Ruvalcaba-Gómez, J.M.; Villagrán, Z.; Valdez-Alarcón, J.J.; Martínez-Núñez, M.; Gomez-Godínez, L.J.; Ruesga-Gutiérrez, E.; Anaya-Esparza, L.M.; Arteaga-Garibay, R.I.; Villarruel-López, A. Non-Antibiotics Strategies to Control Salmonella Infection in Poultry. Animals 2022, 12, 102. [Google Scholar] [CrossRef]
- Wall, B.A. Dynamics and Epidemiology of Antimicrobial Resistance in Animal Production; Food and Agriculture Organization of the United Nations Drivers (FAO): Rome, Italy, 2016. [Google Scholar]
- Altindal, D.; Altindal, N. Chapter 81—Sage (Salvia officinalis) Oils. In Essential Oils in Food Preservation, Flavor and Safety; Preedy, V.R., Ed.; Academic Press: San Diego, CA, USA, 2016; pp. 715–721. ISBN 978-0-12-416641-7. [Google Scholar]
- Ghorbani, A.; Esmaeilizadeh, M. Pharmacological Properties of Salvia Officinalis and Its Components. J. Tradit. Complement. Med. 2017, 7, 433–440. [Google Scholar] [CrossRef]
- Jery, A.E.; Hasan, M.; Rashid, M.M.; Mesfer, M.K.A.; Danish, M.; Rebah, F.B. Phytochemical Characterization, and Antioxidant and Antimicrobial Activities of Essential Oil from Leaves of the Common Sage Salvia officinalis L. from Abha, Saudi Arabia. Asian Biomed. 2020, 14, 261–270. [Google Scholar] [CrossRef]
- Baricevic, D.; Sosa, S.; Della Loggia, R.; Tubaro, A.; Simonovska, B.; Krasna, A.; Zupancic, A. Topical Anti-Inflammatory Activity of Salvia officinalis L. Leaves: The Relevance of Ursolic Acid. J. Ethnopharmacol. 2001, 75, 125–132. [Google Scholar] [CrossRef]
- Saied, E.; Eid, A.M.; Hassan, S.E.-D.; Salem, S.S.; Radwan, A.A.; Halawa, M.; Saleh, F.M.; Saad, H.A.; Saied, E.M.; Fouda, A. The Catalytic Activity of Biosynthesized Magnesium Oxide Nanoparticles (MgO-NPs) for Inhibiting the Growth of Pathogenic Microbes, Tanning Effluent Treatment, and Chromium Ion Removal. Catalysts 2021, 11, 821. [Google Scholar] [CrossRef]
- Ovais, M.; Zia, N.; Ahmad, I.; Khalil, A.T.; Raza, A.; Ayaz, M.; Sadiq, A.; Ullah, F.; Shinwari, Z.K. Phyto-Therapeutic and Nanomedicinal Approaches to Cure Alzheimer’s Disease: Present Status and Future Opportunities. Front. Aging Neurosci. 2018, 10, 284. [Google Scholar] [CrossRef] [PubMed] [Green Version]
- Alagiakrishnan, K.; Sankaralingam, S.; Ghosh, M.; Mereu, L.; Senior, P. Antidiabetic Drugs and Their Potential Role in Treating Mild Cognitive Impairment and Alzheimer’s Disease. Discov. Med. 2013, 16, 277–286. [Google Scholar] [PubMed]
- Wells, R.; Truong, F.; Adal, A.M.; Sarker, L.S.; Mahmoud, S.S. Lavandula Essential Oils: A Current Review of Applications in Medicinal, Food, and Cosmetic Industries of Lavender. Nat. Prod. Commun. 2018, 13, 1403–1417. [Google Scholar] [CrossRef] [Green Version]
- Ali, B.; Al-Wabel, N.A.; Shams, S.; Ahamad, A.; Khan, S.A.; Anwar, F. Essential Oils Used in Aromatherapy: A Systemic Review. Asian Pac. J. Trop. Biomed. 2015, 5, 601–611. [Google Scholar] [CrossRef] [Green Version]
- Khalifa, S.A.M.; Shedid, E.S.; Saied, E.M.; Jassbi, A.R.; Jamebozorgi, F.H.; Rateb, M.E.; Du, M.; Abdel-Daim, M.M.; Kai, G.-Y.; Al-Hammady, M.A.M.; et al. Cyanobacteria—From the Oceans to the Potential Biotechnological and Biomedical Applications. Mar. Drugs 2021, 19, 241. [Google Scholar] [CrossRef]
- Charles, D.J. Antioxidant Properties of Spices, Herbs and Other Sources; Springer: New York, NY, USA, 2013; ISBN 978-1-4614-4309-4. [Google Scholar]
- Candela, R.G.; Rosselli, S.; Bruno, M.; Fontana, G. A Review of the Phytochemistry, Traditional Uses and Biological Activities of the Essential Oils of Genus Teucrium. Planta Med. 2021, 87, 432–479. [Google Scholar] [CrossRef]
- Zaouali, Y.; Messaoud, C.; Salah, A.B.; Boussaïd, M. Oil Composition Variability among Populations in Relationship with Their Ecological Areas in Tunisian Rosmarinus officinalis L. Flavour Fragr. J. 2005, 20, 512–520. [Google Scholar] [CrossRef]
- National Committee for Clinical Laboratory Standards. Performance Standards for Antimicrobial Disk Susceptibility Tests. Approved Standard M2-A6; National Committee for Clinical Laboratory Standards: Wayne, PA, USA, 1998. [Google Scholar]
- Khedher, M.R.B.; Khedher, S.B.; Chaieb, I.; Tounsi, S.; Hammami, M. Chemical Composition and Biological Activities of Salvia Officinalis Essential Oil from Tunisia. EXCLI J. 2017, 16, 160–173. [Google Scholar] [CrossRef]
- Saied, E.M.; El-Maradny, Y.A.; Osman, A.A.; Darwish, A.M.G.; Abo Nahas, H.H.; Niedbała, G.; Piekutowska, M.; Abdel-Rahman, M.A.; Balbool, B.A.; Abdel-Azeem, A.M. A Comprehensive Review about the Molecular Structure of Severe Acute Respiratory Syndrome Coronavirus 2 (SARS-CoV-2): Insights into Natural Products against COVID-19. Pharmaceutics 2021, 13, 1759. [Google Scholar] [CrossRef]
- Gaber, A.; Alsanie, W.F.; Kumar, D.N.; Refat, M.S.; Saied, E.M. Novel Papaverine Metal Complexes with Potential Anticancer Activities. Molecules 2020, 25, 5447. [Google Scholar] [CrossRef]
- Ansari, M.J.; Al-Ghamdi, A.; Khan, K.A.; Adgaba, N.; El-Ahmady, S.H.; Gad, H.A.; Roshan, A.; Meo, S.A.; Kolyali, S. Validation of Botanical Origins and Geographical Sources of Some Saudi Honeys Using Ultraviolet Spectroscopy and Chemometric Analysis. Saudi J. Biol. Sci. 2018, 25, 377–382. [Google Scholar] [CrossRef] [PubMed]
- Jemia, M.B.; Formisano, C.; Bancheva, S.; Bruno, M.; Senatore, F. Chemical Composition of the Essential Oils of Centaurea formanekii and C. orphanidea ssp. thessala, Growing Wild in Greece. Nat. Prod. Commun. 2012, 7, 1083–1086. [Google Scholar] [CrossRef] [PubMed] [Green Version]
- Khan, M.; Mousa, A.A.; Syamasundar, K.V.; Alkhathlan, H.Z. Determination of Chemical Constituents of Leaf and Stem Essential Oils of Artemisia monosperma from Central Saudi Arabia. Nat. Prod. Commun. 2012, 7, 1079–1082. [Google Scholar] [CrossRef] [PubMed] [Green Version]
- Xiao, J.; Zuo, Y.; Liu, Y.; Li, J.; Hao, Y.; Zhou, X. Effects of Nidus Vespae Extract and Chemical Fractions on Glucosyltransferases, Adherence and Biofilm Formation of Streptococcus Mutans. Arch. Oral Biol. 2007, 52, 869–875. [Google Scholar] [CrossRef]
- Giuffrida, A.; Giarratana, F.; Valenti, D.; Muscolino, D.; Parisi, R.; Parco, A.; Marotta, S.; Ziino, G.; Panebianco, A. A New Approach to Predict the Fish Fillet Shelf-Life in Presence of Natural Preservative Agents. Ital. J. Food Saf. 2017, 6, 6768. [Google Scholar] [CrossRef] [Green Version]
- Bhuvaneswa, M.; Shanmughap, S.; Natarajase, K. Prevalence of Multidrug-Resistant (MDR) Salmonella Enteritidis in Poultry and Backyard Chicken from Tiruchirappalli, India. Microbiol. J. 2015, 5, 28–35. [Google Scholar] [CrossRef] [Green Version]
- Khan, N.A.; Nazar, R.; Iqbal, N.; Anjum, N.A. Phytohormones and Abiotic Stress Tolerance in Plants; Springer: Berlin/Heidelberg, Germany, 2012; ISBN 978-3-642-25828-2. [Google Scholar]
- Craft, J.D.; Satyal, P.; Setzer, W.N. The Chemotaxonomy of Common Sage (Salvia officinalis) Based on the Volatile Constituents. Medicines 2017, 4, 47. [Google Scholar] [CrossRef] [Green Version]
- Perry, N.B.; Anderson, R.E.; Brennan, N.J.; Douglas, M.H.; Heaney, A.J.; McGimpsey, J.A.; Smallfield, B.M. Essential Oils from Dalmatian Sage (Salvia officinalis L.): Variations among Individuals, Plant Parts, Seasons, and Sites. J. Agric. Food Chem. 1999, 47, 2048–2054. [Google Scholar] [CrossRef]
- Reverchon, E.; Taddeo, R.; Porta, G. Extraction of Sage Oil by Supercritical CO2: Influence of Some Process Parameters. J. Supercrit. Fluids 1995, 8, 302–309. [Google Scholar] [CrossRef]
- Glisic, S.; Ivanovic, J.; Ristic, M.; Skala, D. Extraction of Sage (Salvia officinalis L.) by Supercritical CO2: Kinetic Data, Chemical Composition and Selectivity of Diterpenes. J. Supercrit. Fluids 2010, 52, 62–70. [Google Scholar] [CrossRef]
- Sellami, I.H.; Rebey, I.B.; Sriti, J.; Rahali, F.Z.; Limam, F.; Marzouk, B. Drying Sage (Salvia officinalis L.) Plants and Its Effects on Content, Chemical Composition, and Radical Scavenging Activity of the Essential Oil. Food Bioprocess Technol. 2012, 5, 2978–2989. [Google Scholar] [CrossRef]
- Ismail, M.A.; Amin, M.A.; Eid, A.M.; Hassan, S.E.-D.; Mahgoub, H.A.; Lashin, I.; Abdelwahab, A.T.; Azab, E.; Gobouri, A.A.; Elkelish, A. Comparative Study between Exogenously Applied Plant Growth Hormones versus Metabolites of Microbial Endophytes as Plant Growth-Promoting for Phaseolus Vulgaris L. Cells 2021, 10, 1059. [Google Scholar] [CrossRef] [PubMed]
- Longaray Delamare, A.P.; Moschen-Pistorello, I.T.; Artico, L.; Atti-Serafini, L.; Echeverrigaray, S. Antibacterial Activity of the Essential Oils of Salvia officinalis L. and Salvia triloba L. Cultivated in South Brazil. Food Chem. 2007, 100, 603–608. [Google Scholar] [CrossRef]
- El Euch, S.K.; Hassine, D.B.; Cazaux, S.; Bouzouita, N.; Bouajila, J. Salvia officinalis Essential Oil: Chemical Analysis and Evaluation of Anti-Enzymatic and Antioxidant Bioactivities. S. Afr. J. Bot. 2019, 120, 253–260. [Google Scholar] [CrossRef]
- Garcia-Gutierrez, E.; Mayer, M.J.; Cotter, P.D.; Narbad, A. Gut Microbiota as a Source of Novel Antimicrobials. Gut Microbes 2018, 10, 1–21. [Google Scholar] [CrossRef] [Green Version]
- Bouarab-Chibane, L.; Forquet, V.; Lantéri, P.; Clément, Y.; Léonard-Akkari, L.; Oulahal, N.; Degraeve, P.; Bordes, C. Antibacterial Properties of Polyphenols: Characterization and QSAR (Quantitative Structure–Activity Relationship) Models. Front. Microbiol. 2019, 10, 829. [Google Scholar] [CrossRef]
- Amit, S.K.; Uddin, M.d.M.; Rahman, R.; Islam, S.M.R.; Khan, M.S. A Review on Mechanisms and Commercial Aspects of Food Preservation and Processing. Agric. Food Secur. 2017, 6, 51. [Google Scholar] [CrossRef]
- Ilie, C.; Golet, I.; Craciunescu, M.; Hogea, E.; Popescu, R.; Horhat, F.G. Chemical Composition and Antimicrobial Activity of Essential Oil of Western Romanian Salvia officinalis. Rev. Chim. 2016, 67, 131–133. [Google Scholar]

| Item | Salmonella enterica | |||
|---|---|---|---|---|
| Inhibition Zone Diameter (mm) | MIC (µg/mL) | |||
| MIC | MIC50 | MIC90 | ||
| Essential Oil a | 21 ± 1.09 | 1 | 2 | 5 |
| DMSO (Negative control) | - | - | - | - |
| Peak No | Compound a | RI b | KI c | Composition (%) |
|---|---|---|---|---|
| 1 | α-Pinene | 938 | 940 | 0.74 |
| 2 | Camphene | 954 | 954 | 0.86 |
| 3 | Myrcene | 994 | 992 | 3.36 |
| 4 | α-Terpinene | 1018 | 1019 | 0.18 |
| 5 | p-Cymene | 1026 | 1025 | 0.72 |
| 6 | Limonene | 1030 | 1030 | 0.42 |
| 7 | 1,8-Cineol | 1035 | 1033 | 39.18 |
| 8 | β-Ocimene | 1040 | 1041 | 0.14 |
| 9 | γ-Terpinene | 1062 | 1063 | 0.12 |
| 10 | α-Terpinolene | 1090 | 1089 | 0.09 |
| 11 | Linalool | 1098 | 1098 | 0.99 |
| 12 | Borneol | 1068 | 1170 | 0.36 |
| 13 | α-Terpineol | 1188 | 1189 | 10.32 |
| 14 | Myrtenol | 1193 | 1194 | 3.13 |
| 15 | Carvone | 1246 | 1248 | 4.25 |
| 16 | Bornyl acetate | 1285 | 1286 | 0.15 |
| 17 | β-Caryophyllene | 1419 | 1419 | 12.8 |
| 18 | α-humulene | 1455 | 1456 | 7.37 |
| 19 | Germacrene-B | 1535 | 1536 | 0.38 |
| 20 | Viridiflorol | 1591 | 1591 | 4.15 |
| 21 | UD e | 1695 | 1695 | 0.23 |
| Identified components (%) | 89.94 | |||
| Monoterpene hydrocarbons | 6.28 | |||
| Oxygenated monoterpenes | 55.73 | |||
| Sesquiterpene hydrocarbons | 20.55 | |||
| Oxygenated sesquiterpenes | 4.15 | |||
| Oil yield (%) (v/w) 0.45 | ||||
Publisher’s Note: MDPI stays neutral with regard to jurisdictional claims in published maps and institutional affiliations. |
© 2022 by the authors. Licensee MDPI, Basel, Switzerland. This article is an open access article distributed under the terms and conditions of the Creative Commons Attribution (CC BY) license (https://creativecommons.org/licenses/by/4.0/).
Share and Cite
Selim, S.; Almuhayawi, M.S.; Alqhtani, H.; Al Jaouni, S.K.; Saleh, F.M.; Warrad, M.; Hagagy, N. Anti-Salmonella and Antibiofilm Potency of Salvia officinalis L. Essential Oil against Antibiotic-Resistant Salmonella enterica. Antibiotics 2022, 11, 489. https://doi.org/10.3390/antibiotics11040489
Selim S, Almuhayawi MS, Alqhtani H, Al Jaouni SK, Saleh FM, Warrad M, Hagagy N. Anti-Salmonella and Antibiofilm Potency of Salvia officinalis L. Essential Oil against Antibiotic-Resistant Salmonella enterica. Antibiotics. 2022; 11(4):489. https://doi.org/10.3390/antibiotics11040489
Chicago/Turabian StyleSelim, Samy, Mohammed S. Almuhayawi, Hussain Alqhtani, Soad K. Al Jaouni, Fayez M. Saleh, Mona Warrad, and Nashwa Hagagy. 2022. "Anti-Salmonella and Antibiofilm Potency of Salvia officinalis L. Essential Oil against Antibiotic-Resistant Salmonella enterica" Antibiotics 11, no. 4: 489. https://doi.org/10.3390/antibiotics11040489
APA StyleSelim, S., Almuhayawi, M. S., Alqhtani, H., Al Jaouni, S. K., Saleh, F. M., Warrad, M., & Hagagy, N. (2022). Anti-Salmonella and Antibiofilm Potency of Salvia officinalis L. Essential Oil against Antibiotic-Resistant Salmonella enterica. Antibiotics, 11(4), 489. https://doi.org/10.3390/antibiotics11040489

